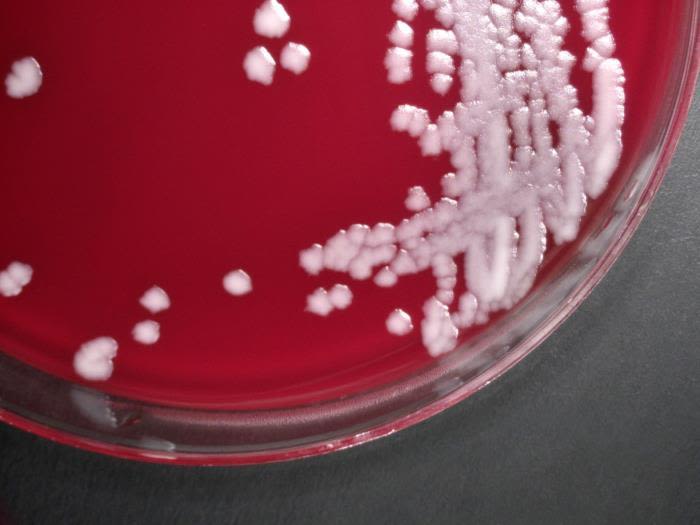
Anthrax bacterial culture in a petri dish.

New Approach to Tackle Biological Threat Agents, COVID-19 & Antimicrobial Resistance Using Pathogen Capture Technology


SUMMARY
Despite the success in developing antibiotics and antimicrobials over the past century, there are concerns regarding new and emerging infections diseases, security threats from biological agents and antimicrobial resistance. All current strategies for disinfection and decontamination of pathogenic microorganisms are over a century old and are unsustainable due to harsh chemicals, that are unsafe on the skin and toxic to the environment. They are aiding in the rise of resistant pathogens, posing threat to the environmental microbiome and aquatic life and cause allergies, dermatitis, respiratory illnesses and female hormone disruption. Research at the University of Galway led to an anti-adhesion technology that neutralises virus and bacteria so they cannot attach to human cells to cause infection. Aquila Bioscience has developed ‘Pathogen Capture Technology (PCT)’, which is free from toxic chemicals and is demonstrated to capture and remove ~99.99% of pathogens to control infectious pathogens including SARS-CoV-2, influenza, MRSA, and biological threat agents such as anthrax and ricin. Aquila Bioscience’s products have been used by some of the European defence agencies, private industries in healthcare as well as consumers to keep their families and loved ones safe from infectious diseases without using harmful chemicals.
Pathogen Capture Technology (PCT)
Anthrax, a potent biological threat agent, poses serious risks to human health. The growing challenge of antimicrobial resistance underscores the urgent need for innovative, non-toxic pathogen capture technologies. (Credit: CDC/Todd Parker, Ph.D.)
Anthrax, a potent biological threat agent, poses serious risks to human health. The growing challenge of antimicrobial resistance underscores the urgent need for innovative, non-toxic pathogen capture technologies. (Credit: CDC/Todd Parker, Ph.D.)
Professor Lokesh Joshi, Stokes Professor of Glycosciences at the University of Galway and founder of Aquila Bioscience Ltd, leading groundbreaking research in biomimicry and pathogen capture technology
Professor Lokesh Joshi, Stokes Professor of Glycosciences at the University of Galway and founder of Aquila Bioscience Ltd, leading groundbreaking research in biomimicry and pathogen capture technology
Molecular structure of a glycan: complex carbohydrate molecules like these play a crucial role in cell-cell communication and pathogen interactions. AquilaBio’s PCT leverages glycan-protein interactions to neutralise and remove harmful microbes.
Molecular structure of a glycan: complex carbohydrate molecules like these play a crucial role in cell-cell communication and pathogen interactions. AquilaBio’s PCT leverages glycan-protein interactions to neutralise and remove harmful microbes.
The SARS-CoV-2 virus, with its spike (S) proteins. AquilaBio’s Pathogen Capture Technology (PCT) targets these proteins to neutralise the virus and prevent infection.
The SARS-CoV-2 virus, with its spike (S) proteins. AquilaBio’s Pathogen Capture Technology (PCT) targets these proteins to neutralise the virus and prevent infection.
Defence Forces Ireland were key collaborators in the development and validation of AquilaBio’s Pathogen Capture Technology for protection against biological threats
Defence Forces Ireland were key collaborators in the development and validation of AquilaBio’s Pathogen Capture Technology for protection against biological threats
Research Description
Infectious diseases pose a global threat that requires urgent attention. The threat comes from the new and emerging infectious agents (such as SARS-CoV-2 and avian/swine influenza), antimicrobial-resistant bacteria (such as MRSA) and biological threat agents (such as anthrax). Excessive use of antibiotics has allowed microorganisms to adapt and survive selective pressures. Microorganisms also persist on environmental surfaces such as reservoirs and the use of strong chemicals in disinfectants and hygiene products (e.g. bleach, alcohol and ammonium-based compounds) has also put microbes under selective pressure and therefore has aided in genetic mutations and resistant microbes. As such it is obvious that alternative safer and sustainable strategies are urgently required to protect human health. Regulatory agencies, including the US FDA, have recognised the harmful effects of current disinfectants and have begun to restrict their use. More details can be found in the Federal Register: US FDA Regulation on Antiseptic Products.
Professor Lokesh Joshi is a Stokes Professor of Glycosciences at University of Galway and is the founder of a University spin out company, Aquila Bioscience Ltd (AquilaBio) . Prof Joshi has a particular interest in Biomimicry - more specifically identifying strategies found in nature and utilising them to solve human challenges which is the approach used in AquilaBio’s technology.
One key requirement for microorganisms to cause infection is the requirement to adhere to cells. All cells on the planet are coated with specific proteins and carbohydrates called glycans, essentially alphabets of a chemical language used by cells to either attach to or detach from each other. This applies to all microbes as well, such as viruses, bacteria and fungi, including antimicrobial-resistant microbes, which use carbohydrates and proteins to attach to the host cells. Efficient and stable adhesion is a prerequisite for colonisation and invasion of cells.
Prof. Joshi and his team study the role of sugar/glycan-protein interactions in cell-cell communication, including host-microbe relationship (R1). It is well known that nature has equipped animals (including humans) with the ability to produce highly complex molecules, such as mucins, to trap and remove microbes that may cause harm to us (R2). With this knowledge, AquilaBio has developed anti-adhesion technologies (R3) which mimic nature by using complex glycans (sugar molecules) specifically designed to attach to proteins on pathogens – such as the ‘corona’ spikes of the SARS-CoV-2 virus and bacterial proteins. Once the glycans are attached, the virus and bacteria become neutralised and are unable to attach to human cells, preventing infection. This strategy works like a nanoscale ‘biological velcro®’, where molecules bind to and remove pathogens without the use of harmful chemicals such as alcohol, bleach, or ammonium-based compounds.
Over the past decade, AquilaBio has developed its Pathogen Capture Technology in collaboration with the Defence Forces Ireland and the Czech University of Defence, with support from the European Defence Agency and European Union funding, to combat biological threat agents and biotoxins (R4). At the beginning of COVID-19, AquilaBio was funded by the European Innovation Council and began manufacturing pilot products to support the frontline agencies in their battle against COVID-19. During this period, AquilaBio’s technology was tested and proven effective against SARS-CoV-2 to decontaminate human skin and it was tested in a number of antimicrobial-resistant bacteria. Patent protection has been filed for Aquila’s Pathogen Capture Technology and is currently under the nationalisation phase for patent protection in USA, Canada, Mexico, the UK, Europe, China, India, South Korea and Australia (R5).
Details of the Impact
University of Galway licensed key enabling know-how to the spin-out company Aquila Bioscience Ltd, founded by Prof. Joshi, to ensure it was positioned to maximise the expertise and experience built over a decade of research at the University. AquilaBio is a Biomedical Research & Development SME located at University of Galway Innovation Centre, has further developed the Pathogen Capture Technology (PCT) (E1). The company has developed two unique pilot products: the Anti Bioagent Decontamination (ABD) Device and Pro-Shield Spray. The ABD Device is a cellulose-based decontamination wipe that incorporates natural binders that captures and removes all pathogens including viruses, bacteria, fungi and their mutants in a safe and effective manner. The technology consists of non-toxic chemicals that can be safely used on sensitive skin surfaces such as face, around the eyes, nose and mouth and mucosal surfaces to disinfect these ports of entry from pathogens. Pro-Shield spray was originally developed to be sprayed on fabric masks to reduce the use of disposable plastic-based masks, which have become a significant environmental pollutant.
Economic Impact
In 2020, AquilaBio received €2.7m through a European Innovation Council’s (EIC) Accelerator Award (R4), which has allowed AquilaBio to make further progress on manufacturing and further testing of its unique PCT for the production of commercially available products. This funding enabled AquilaBio to translate a laboratory prototype to a commercial-scale manufacturing environment. Since 2020, AquilaBio has been registered as a foreign manufacturing facility for the ABD Device with the FDA under Owner/ Operator Number 10074735. The product is a US FDA registered Class I medical device (2020) that comes in the form of a sterile decontamination wipe, giving AquilaBio access to the US market.
As of 2023, AquilaBio employed 15 Research and Development staff and had secured over €4 million in research funding. In April 2020, AquilaBio’s first IP protected (R5) product ABD device was delivered to its first customer, Defence Forces Ireland (E3). Lt. Col. Ray Lane (Retd) Defence Forces Ireland, remarked:
“I am fully aware of the potential threats posed by biological agents and the lack of tools and technologies to protect us. Professor Joshi and his team in Aquila Bioscience have developed a revolutionary and yet safe and environmentally sustainable technology for the protection against not just biothreat agents but all other infectious agents.” (E5)
Since then, ABD devices have been delivered globally to a number of organisations (details confidential). ABDs have now been used by Irish frontline workers in the defence forces, healthcare, nursing homes, postal services and other settings, protecting the most vulnerable members of society. ABD devices have also been procured by other European defence forces (E6). Comments from users show how the products benefit their organisations:
“It gives us another tool to use during the pandemic to ensure we can stay open and keep our staff and patients safe” (E7).
The company’s second product ProShield was launched to the market in March 2021. The company continues to grow supplying its products to various first-responder agencies in Europe, Private healthcare providers, companies, and consumers (confidential). Under strict confidentiality agreements, AquilaBio is also engaging with other market leaders in bringing its technology to other sectors for healthcare, consumer care and industrial applications.
Health and Environmental Impacts
All of the currently used decontamination products contain synthetic chemicals such as alcohol, peroxides and chlorine or ammonium-based chemicals such as bleach and Benzalkonium Chloride. These chemicals have been in use for over a century with little or no innovation and they are not only harmful to human health, but also for the environment. In addition, their manufacturing has a serious negative impact on the environment. The US FDA has studied the data on currently marketed chemicals for disinfection and sanitisation and has restricted the use of most of these chemicals under prescription only (http://federalregister.gov/a/2016-21337). This has led the industry to actively seek alternative solutions that do not pose health and environmental risk.
AquilaBio took inspiration from nature that does not use toxic chemicals to keep animals (including humans) safe from all types of pathogens by producing a range of molecules that are designed to trap and remove the pathogens we encounter every day. Over the past decade AquilaBio has collaborated with the Defence Forces Ireland to understand the challenges and the requirements of the ‘end user’ and with the Czech defence researchers to develop and validate the technology with real live biological agents under stringent biological safety conditions. AquilaBio has developed technology and products that are free from toxic and harmful chemicals, they are effective and are environmentally sustainable, to support front-line personnel to vulnerable elders and babies from harmful microbes - underpinning AquilaBio’s commitment to supporting UN Sustainability Development Goals (SDGs) by developing environmentally sustainable and safer healthcare technologies for the protection against infectious diseases. AquilaBio uses natural biodegradable components in its PCT which is not the case for all other decontamination products in the market. Most other decontamination products use chemicals that have well recorded negative impact on the environment (E4).
Gerlof de Wilde, Seconded National Expert to the European Commission Joint Research Centre, Defence advisor to the Observatory of Critical Technologies commented
“this has been one of the most innovative and elegant solutions for decontamination of bio threat agents. The European Union needs more technologies for the protection of its military, the security forces, first responders and civilians against potential CBRN threats.” (E6)
AquilaBio has supported defence agencies, nursing homes, undertakers, clinical trial teams, as well as immunocompromised people and families. As recently as autumn 2023, AquilaBio supported the Greek first responder teams during the severe floods in parts of Greece that caused major loss of farm animals with possible risk of the spread of infectious diseases.





Research Funding
This research was supported by funding from the European Union’s Horizon 2020 research and innovation programme under grant agreement No 959436.

References to the Research
- R1. Utratna, M., Annuk, H., Gerlach, J.Q. et al. Rapid screening for specific glycosylation and pathogen interactions on a 78 species avian egg white glycoprotein microarray. Sci Rep 7, 6477 (2017). https://doi.org/10.1038/s41598-017-06797-6
- R2. Baddr Shakhsheer, Mark Anderson, Khaled Khatib, Leelapavan Tadoori, Lokesh Joshi, Frederique Lisacek, Lynette Hirschman, Elaine Mullen. SugarBind database (SugarBindDB): a resource of pathogen lectins and corresponding glycan targets. J Molecular Recognition Volume26, Issue9, September 2013, Pages 426-431. https://doi.org/10.1002/jmr.2285
- R3. Utratna M, Deegan S, Joshi L. Exploitation of Glycobiology in Anti-Adhesion Approaches against Biothreat Agents. J Bioterror Biodef 2016;7(2). Paper describing Adhesion technology. DOI: 10.4172/2157-2526.1000150
- R4. Cordis Europa COVID-19 pandemic: An innovative, safe and effective bio-decontamination technology for non-toxic removal of biological agents, including coronavirus. Project results page from EIC grant
- R5. Utratna Marta, Joshi Lokesh - Device and method for decontamination- International Patent Application WIPO 2020/240027 A1. Device and method for decontamination / disinfection. Accessed 04/04/2024
Evidence of Impact
- E1. Aquilla Biosciences. Company Website accessed 04/04/2024
- E2. NeoVirTech. 2020. Case study: Disinfection testing on living human skin. [accessed 04/04/2024. Report from independent laboratory confirms product claims
- E3. Article: First consignment of Galway-manufactured wipe that can help fight Covid-19 delivered to Defence Forces
- E4. Evidence of toxicity of current solutions: Naseeba Parveen, Shamik Chowdhury, and Sudha Goel: Environmental impacts of the widespread use of chlorine-based disinfectants during the COVID-19 pandemic. Environ Sci Pollut Res Int. 2022; 29(57): 85742–85760. Hong Zhang , Wenzhong Tang, Yushun Chen, and Wei Tin. Disinfection threatens aquatic ecosystems. SCIENCE. Vol 368, Issue 6487. pp. 146-147 Maillard, JY., Pascoe, M. Disinfectants and antiseptics: mechanisms of action and resistance. Nat Rev Microbiol 22, 4–17 (2024). https://doi.org/10.1038/s41579-023-00958-3
- E5. Testimonial from Lt. Col. Ray Lane (Retd), Defence Forces Ireland
- E6. Testimonial from Gerlof de Wilde, Seconded National Expert to the European Commission Joint Research Centre, Defence advisor to the Observatory of Critical Technologies.
- E7. Testimonial from Errigal Dental.